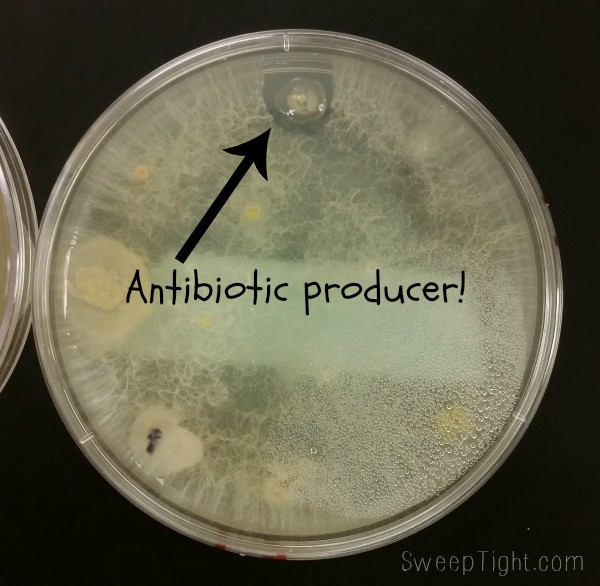

Top 10 Sleep Distractions and How To Squish Them
Everyone seems to take sleep for granted nowadays. We all justify losing it over work, relationship drama, TV shows, books, chores… While we are all juggling these wretched sleep distractions, we must not forget how important sleep is for our bodies, minds, and souls. This post is sponsored by Restonic, all thoughts and opinions shared are my own.
My Top 10 Sleep Distractions
10. Work. It never ends. I sacrifice precious potential sleep hours getting work stuff done pretty much every day.
9.5. Blogger. When do bloggers actually sleep? I really don’t think some of them ever do. Ever.
9. School. Because homework. See number 10.
But, on the bright side, we’re doing some really neat stuff in school. Like looking for new antibiotics. 😀 Yeah, I’m a huge nerd and think this is super fun. That little guy up there is going under further study.
8. Laundry. Someone in my house seems to be wearing 16 outfits a day.
7. Cat. Right about the time for bed, Stewie seems to think it’s party time. The sound of his back claws desperately trying to gain traction on the wood floors as he catapults himself all around the house, isn’t exactly a relaxing lullaby.
6. Beautifications. I try to have good skin hygiene and wash my face right before bed every night. But then there’s eye cream, face cream, lip cream, and wait, are those tweezers? Pardon me while I mutilate and pluck every pore on my face for 30 minutes.
5. Reading. Darn these super interesting fictional characters! Your make believe world is intoxicating and I want to live there.
4. Caffeine. To make it through that infernal night class, I thought a cup of coffee at 6:30 pm would be a good idea.

3. Email. Because for the love of all that is Holy, if I don’t keep up with it multiple times a day, my mailbox would make you think I’m a celebrity. But, oh yeah, I’m not. Back to that beauty sleep…
2. To Do Lists. Right about the time I would be falling asleep, I feel the need to write down everything I need to do the next day to make sure I don’t forget anything. This usually just means recopying everything from today’s list onto a new piece of paper. Respect the process.
1.8. Kids. Because it’s always awesome when you’re trapped in the house with your adorably disgusting child that may have given you lice. With an off the charts heebie-jeebie factor, you better just treat your own head to be safe.

 I thought once they weren’t babies any more I’d be able to sleep in peace?!
1.4. ADHD. I think I have it. Seriously. Maybe I just need more sleep…

1. MY PHONE. My smart phone is trying to kill me. It tries to distract me while driving. It won’t leave me alone while I’m performing important tasks like using the bathroom. IT’S ALWAYS NEAR ME! It wakes me up. It prevents me from falling asleep. Yet, despite all these attempts at my life, I depend on it for everything.
Squish ‘Em All!
First of all, we all need to show more respect for sleep. It boosts our immune systems, makes us look and feel healthy, and allows us to focus on all the million things we’ve got going on. Let’s squish all these sleep distractions once and for all.
It is for this reason, I am setting up my charging station on the other side of the bedroom. I won’t be tempted to check emails, social media statuses, watch funny cat videos, play games, or watch all my friends’ Snapchats while lying in bed.
Instead of recopying my ridiculous to-do lists everyday, I am putting them all into an app that has a built in timer to keep me on task.
That leads me to another tip for time management. Timers for me are magical. They help me stay on task and spend my time wisely, so I actually have time to sleep. So I allot certain amounts of time for homework, blog work, chores, emails… etc.
As for the kids, well, I suppose they’re worth losing a little sleep over. 😉 Stewie on the other hand… I’ll be playing some soft nature sounds to drown out his playful nighttime noises.
I will no longer have anything with caffeine after noon. I figure, if I’m getting more sleep at night, I won’t need it anyway!
I’ve saved the best for last:
Make yourself a seductive sleep sanctuary with a quality mattress, comfy pillows and cozy blankets.
Restonic came up with a brilliant mnemonic device to remind us just how important sleep is.

How do you make sure to get enough sleep?
Disclosure: I am part of the PTPA Brand Ambassador Program with Restonic and I received Compensation as part of my affiliation with this group. The opinions on this blog are my own.

I don’t take caffeine & eat few hours before bedtime as well as exercise.
I love this post lol! It’s like you read my mind!! I don’t even bother trying to get more sleep because I know it’ll never happen until my kids are outta my house lol
I just got a lovely CD that put me right to sleep last night. No electronics for an hour before bed.
Lol. I have some of the same problems! Especially the tweezers and the phone! Total OCD! Thanks for the chuckle and great tips. 🙂
Homework and reading are two distractions from your list that I can attest to. Homework can’t be helped, I mean you have to do your homework. But when you really get into a good book and you just can’t put it down? I’ve found myself reading until two or three in the morning, and having to force myself to PUT THE BOOK DOWN and go to sleep.
I have problems sleeping and wait until menopause when you can get hot flashes that wake me up! I exercise which really does help me sleep more soundly, and I make myself stay in bed longer because it really helps!
Good morning Shelley,
How did you sleep last night? Wow, sounds like you’ve got a good handle on what’s robbing you of a good night’s sleep and how to win back the night. Between work, parenting and all the other little things that fill our lives, getting a good night’s sleep can be almost impossible. We’re looking forward to reading your next post and seeing how the changes you’re making affect your mood and health.
You might enjoy these TED videos on the importance of a good night’s sleep:
Good luck!
Julia
If your mind won’t shut off, get up and make a todo list and then forget about it.
I was sitting here reading your post and started looking around my bedroom, my computer is in the bedroom, and decided to help me sleep better I am going to make my bedroom a sleep sanctuary. It’s time to spring clean my room by getting rid of a bunch of junk and get some new bedding, curtains for the windows and maybe some nice pictures on the walls. I can’t wait to get started.